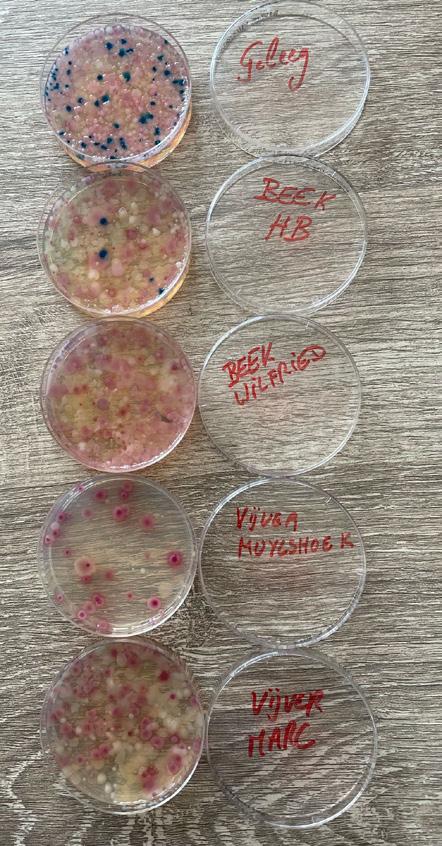

Rivierengebied & De Putter

Leden van Natuurpunt Mechels Rivierengebied en Natuurpunt De Putter ontvangen dit driemaandelijks tijdschrift gratis. Andere Natuurpuntleden kunnen voor 2026 een abonnement nemen door 8 euro over te schrijven op rekening BE42 0013 6468 8754 met als vermelding ‘tijdschrift 2026’.
NATUURPUNT DE PUTTER
Natuurpunt De Putter telt 380 leden en is actief in Putte. Een team van gedreven vrijwilligers maakt daar werk van meer en betere natuur.
Contactpersoon
Natuurpunt De Putter
Lucien Verschoren (voorzitter afdeling) 0496 98 64 39, lucien.verschoren@telenet.be Website en Facebook putter.natuurpuntdeputter.be www.facebook.com/p/Natuurpunt-De-Putter-100076862240752
Digitaal afdelingsnieuws
Planten- en dierenwaarnemingen in de regio: www.mechelen.waarnemingen.be
NATUURPUNT MECHELS RIVIERENGEBIED
Giften - Reservatenfonds
Schrijf je gift over op rekening BE56 2930 2120 7588 van Natuurpunt met vermelding ‘project 3716 De Putter.' Vanaf 40 euro wordt een fiscaal attest afgeleverd.
Lid worden
Het lidgeld bedraagt 38 euro per gezin tot eind 2026. Overschrijven op rekening BE17 2300 0442 3321 BIC GEBABEBB van Natuurpunt, met vermelding ‘(nieuw) lid via De Putter’.
Dankzij meer dan 4200 leden en een stevige ploeg vrijwilligers werkt Natuurpunt Mechels Rivierengebied aan de bescherming en verdere ontwikkeling van de natuur in Bonheiden, Mechelen, Sint-Katelijne-Waver en Willebroek. Digitaal afdelingsnieuws
Contactpersonen
Natuurpunt Mechels Rivierengebied
Jorn Van de Velde, 0493 02 96 97, jorn.vandevelde@gmail.com
Kern Mechelen np.kernmechelen@gmail.com
Kern Bonheiden
Joost Dewyspelaere, 015 51 69 97, joost.dewyspelaere@skynet.be
Kern St.-Katelijne-Waver
Godelieve Janssens, 015 20 97 02, godelieve-jans@telenet.be
Kern Willebroek
Wim Candries, 0472 29 87 32
Website, Facebook en Twitter www.natuurpunt.be/mechelsrivierengebied www.facebook.com/NatuurpuntMechelsRivierengebied twitter.com/NatuurMechelen
Bezoekerscentrum


Planten- en dierenwaarnemingen in de regio: www.mechelen.waarnemingen.be
Activiteitenflits: aanvragen via de startpagina van onze website www.natuurpunt.be/np-mrg
Giften - Reservatenfonds
Schrijf je gift over op rekening BE56 2930 2120 7588 van Natuurpunt met vermelding ‘project 3799 Mechels Rivierengebied’. Vanaf 40 euro wordt een fiscaal attest afgeleverd.
Lid worden
Het lidgeld bedraagt 38 euro per gezin tot eind 2026. Overschrijven op rekening BE17 2300 0442 3321 BIC GEBABEBB van Natuurpunt, met vermelding ‘(nieuw) lid via Mechels Rivierengebied’.
Muizenhoekstraat 7, 2812 Muizen bc.mechelsrivierengebied@natuurpunt.be 015 43 61 09 - www.natuurpunt.be/bc-mrg
Openingsuren
Elke ZO 10u - 17u30 (vanaf maart 9u30 - 17u30)
Schoolweken: ook DO 13u30 - 17u30
Kerstvakantie: ook MA, DO en ZA 13u30 - 17u30
Krokusvakantie: ook elke weekdag en ZA 13u30 - 17u30
• info over de lokale natuurgebieden en activiteiten
• wandelbrochures, SNU!T-tas, luister- en zoektochten
• kleine winkelhoek
• biosapjes, biobieren, koffie & thee
Parkeren in Muizen kan langs de Brugstraat en de Rijmenamsesteenweg of op de randparkings Muizen-Dorp, kerkhof Kerkenbos of station Karolingenstraat. © Tony Van den Broeck
WERKTEN MEE AAN DIT NUMMER
Teksten: Diane Appels, Kristine Boey, Wim Candries, Annelies Ceuppens, Peter Delvaux, Peter De Ridder, Frank De Roover, Gust De Weerdt, Mario Engels, Frank Hadermann, Peter Hendrickx, Godelieve Janssens, Erik Maquoi, Rudy Meeus, Bert Mestdagh, Ann Pinceel, Jos Theunis, Walter Van Camp, Jorn Van de Velde, Filip Van den Wyngaert, Koen van Vooren, Robin Verachtert, Myrtle Verhaeven, Lucien Verschoren, Johan Waumans
Redactie: redactie-mrg@natuurpunt.be
DRUK
Buroform nv - www.buroform.be
Oplage: 4570 exemplaren
Cover: wijfje bruine kiekendief © Dirk Vervaeck (vooraan) RUN FOR NATURE 2026 © Natuurpunt (achteraan)
LEDENADMINISTRATIE
www.natuurpunt.be/controlepaneel/mijn-gegevens webformulier: www.natuurpunt.be/contacteer-natuurpunt ledenadministratie@natuurpunt.be, 015 29 72 17
Woordje vooraf
Beste Natuurpunters
De bomenkap in Deurne heeft de nationale pers gehaald. Er was dagenlang protest van honderden buurtbewoners. Zij beseften de waarde van schaduwrijke bomen tijdens de talrijker wordende hittegolven, dat volwassen bomen een weldoende invloed hebben op mensen en dat ze een huis bieden aan vogels en insecten.
Met corona was bijna iedereen overtuigd dat de natuur belangrijk is. Nooit zagen we zoveel wandelaars in onze gebieden en ook de eigen tuin werd herontdekt. Bomen, planten en natuur zijn noodzakelijk voor onze gezondheid.
Er was toen een grote vraag naar bomen en planten, liefst nog vruchtdragend en inheems. Ook de Vlaamse regering en Europa hebben doelen gesteld naar bijkomende bossen: 3 miljard bomen in Europa en 10.000 ha bos erbij in Vlaanderen tegen het jaar 2030.
We hebben in Putte in drie jaar tijd meer dan 20 ha kunnen bebossen en 40.000 jonge boompjes geplant. We hebben dat samen gedaan met vele bedrijven, met buurtbewoners, met verenigingen en met scholen. Deze plantacties werden algemeen aanvaard en gewaardeerd. De pers bracht heel graag verslag uit met artikels en reportages.
Het verschil met dit jaar is groot. Dit jaar planten we in Putte nog 1 ha met twee bedrijven. Daarna is er niks meer in het verschiet; we hebben geen gronden meer beschikbaar, vooral door het wegvallen van subsidies. Dit jaar hebben we niet veel tijd meer want het plantseizoen voor nieuwe bomen, houtkanten en hagen loopt nog tot eind maart.
De beste tijd om een boom te planten was 20 jaar geleden, de tweede beste tijd is nu!
Spijtig genoeg is ons milieu en onze natuur nu minder actueel. Sociale media en sommige politici zwijgen liever over klimaat en natuur of erger…
Natuurpunt is een sterk merk en dat moeten we zo houden of nog versterken. Onze duizenden gezinsleden en de honderden vrijwilligers zetten zich dagdagelijks in voor de natuur, zij verdienen alle lof en respect van iedereen.
De natuur en wijzelf zijn het waard, doe zo voort!
Lucien
Afdelingsvoorzitter De Putter

boomaanplant © PSA Belgium
In dit nummer
2 colofon
3 woordje vooraf inhoud
4 terugblik
8 nieuwtjes
13 dank je wel 1
14 beleidsnieuws
16 gesignaleerd
18 werken in Den Battelaer
20 kalender
22 wist je dat?
24 SNU!T
26 de natuur in
30 beheer
32 inventariseren Kauwendael
34 vorming
35 dank je wel 2
36 cryptogram - online lezen
37 dank je wel 3
38 waarvan akte
39 natuurgebieden



19 oktober Veldcafé Kunstavontuur in het Mechels Broek
© Nils Joossens
26 oktober Bomenfietstocht in Bonheiden
© Luc De Coninck © Isabelle Wuytens
Terugblik
5 oktober Klimaatmars

19 oktober Donateurswandeling
Op een perfecte oktoberse herfstzondag verzamelt ’s ochtends een vijftigtal deelnemers voor onze jaarlijkse donateurswandeling. Naar goede gewoonte nodigt Mechels Rivierengebied zijn donateurs uit om ter plaatse te kijken hoe hun giften ingezet worden voor meer natuur. Dit jaar gaan we – hoe kan het ook anders – op wandel langs het Muysenhuys en de vorig jaar aangekochte gebieden in het Mechels Broek en Mispeldonk. Een aankoop waarvoor we giften hard nodig hebben om deze toch wel grote investering te financieren.
Verschillende Natuurpunters van onze afdeling, net als die van vele andere afdelingen, waren aanwezig op de Klimaatmars in Brussel. Samen met Natagora vestigde Natuurpunt daar de aandacht op de link tussen biodiversiteit en klimaat. Want enerzijds lijdt onze natuur door de veranderende weerpatronen, anderzijds is de natuur ook een oplossing om de CO2-uitstoot te beperken én de gevolgen van klimaatverandering in te perken. Dankzij de mooie, grote aanwezige groep hopen we deze ideeën voldoende in de kijker te hebben gezet!

Heel wat thema’s komen aan bod, van de jarenlange onderhandelingen tot hoe alles vorig jaar plots in een stroomversnelling kwam. Over de historische waterburcht die het huidige kasteeltje voorafging tot de plannen met het kasteelpark en boomaanplant op een vroegere maisakker dit najaar.
Na de wandeling werden ideeën uitgewisseld bij een drankje en een hapje.
Met dank aan alle donateurs die dankzij hun gulheid deze aankopen mogelijk maken.
2 november Boomplantactie in de Warande
In een samenwerking tussen Chiro Battel, Natuur- en Landschapszorg en het lokale beheerteam werd een boomaanplanting gerealiseerd in de Warande. Zoals reeds bericht in ons vorige nummer is dit een pas geopend nieuw natuurgebied van 12 ha tussen de Battelaer en het Robbroek. We opteren hier voor de ontwikkeling van een meer natuurlijk bos ter opvolging van het (deels gerooide) productiebos van Canadapopulieren.
Vanaf volgende lente zal de wandelaar bij de ingang van het gebied en langs het wandelpad een zoom van eenstijlige meidoorn, gele kornoelje, Gelderse roos, lijsterbes en kardinaalsmuts opmerken. Hier en daar werden ook wolkjes zwarte els aangeplant.
© Robin Verachtert
Muysenhuys © Mario Engels
23 november Nieuwe aanplant aan de Steenbeek in Putte

Op 23 november kwam een groep enthousiaste wandelaars kijken naar het nieuw aangeplante bos aan de Steenbeek te Putte: een jong bos van 1 hectare met 2000 bomen. De vele soorten zijn aangepast aan natte gronden: es, els, olm, zomereik, verschillende wilgensoorten waaronder bos-, schiet- en geoorde wilg. In de vallei van de Itterbeek beheren we ook 13 hectare bos en bloemenweides. Het was interessant om bossen van 23 jaar, van 6 jaar en van 2 jaar onderling te vergelijken. Vele zang- en trekvogels werden opgemerkt. De aanwezigheid van bevers en enkele nesten van Aziatische hoornaar zijn nieuw voor dit gebied. Ondanks de regen, de wind en de kou genoot iedereen van de mooie wandeling. Veel dank aan Roger en Liliane.
23 november Een halve hectare nieuw bos op Mispeldonk
Op Mispeldonk (grondgebied Mechelen) plantten we een halve hectare bos. Dit deden we samen met de werknemers van het bedrijf Cargill. Maar liefst 1000 boompjes gingen in slechts twee uur tijd de grond in. Wat een prestatie!
Heel erg bedankt aan alle werknemers van het bedrijf om tijdens het weekend tijd vrij te maken om dit stuk bos mee te realiseren. En ook aan onze vrijwilligers om de plantactie mee in goede banen te leiden.
1 december
Pablo, de otterspeurhond vindt de spraints
Begin december was er een excursie in de Biezenweiden/ Broek De Naeyer Willebroek met een demo otterspeurhond. In het kader van het interregproject ‘Otter over de grens’ (Vlaanderen-Nederland) kwamen enkele leden van het INBO en de Provincie naar Willebroek om ons kennis te laten maken met een ecologische zoekhond.
Pablo, een Beierse bergzweethond, werd gedurende meer dan zes maanden getraind om ‘spraints’ (uitwerpselen van een otter) op te sporen.
Op deze manier kan het labo van het INBO via DNAonderzoek weten waar otters zich bewegen, of het steeds dezelfde otters zijn die langskomen, wat ze eten, het geslacht, de frequentie van hun aanwezigheid en vervuiling via de spraints vaststellen. Het zoeken en speuren gebeurt voornamelijk in de winter- en paarperiode want dan bakenen de otters hun territorium extra af tegen de concurrenten. Dan is er grotere kans om ook uitwerpselen te vinden.
Aan het Zennegat werden begin november twee faunatrappen (fups = fauna uittreedplaatsen) geplaatst zodat de otter via een trap de Leuvense vaart kan verlaten aan de ophaalbrug

Pablo © Jos Theunis
© Liliane Verhulsel
en dan via de weg of een trap tegen de betonnen ringdijkmuur het overstromingsgebied en de Dijle kan bereiken.
In Wintam aan het zeekanaal werden ook negen faunatrappen gezet. Een prachtig initiatief.
11
oktober
20 jaar Biezenweiden
De Biezenweiden, van landbouwgrond naar natuurgebied!
Wanneer het poortje achter je dichtvalt en je via het wandelpad langzaam het bos betreedt, lijkt het of het hier altijd bos is geweest. Alhoewel een opmerkzame wandelaar hier en daar nog restanten van het oude landschap zal opmerken in de vorm van knotwilgenrijen, sloten en hooiweiden. Maar de bomen die je hier aantreft zijn nog maar enkele generaties oud. Dit oorspronkelijke weidelandschap, gelegen in de Rupelvallei bij Heindonk, werd na eeuwen van landbouwgebruik verlaten. De rendabiliteit was niet voldoende voor de moderne landbouw van na de 2de wereldoorlog. Enkele weilanden werden beplant met populieren. Op andere delen mocht de natuur zijn gang gaan, met spontane verbossing tot gevolg.
In 2004 kocht Natuurpunt de Biezenweiden en startte met het beheer. In 2005 organiseerden we een feestelijke opening van de wandelpaden. Het productiebos is, onder zorgvuldig beheer, geleidelijk veranderd naar een gevarieerd natuurgebied: een bosgebied te midden van een zeer waterrijke omgeving. Het is de thuis voor buizerds, boomvalken en spechten. Ook de grote bonte specht en kleine zangvogels zoals de zwartkop kan je hier vinden. De bever en de otter hebben hun weg er naartoe gevonden en reeën verschansen zich overdag in de ondoordringbare stukken. En in de Zwarte beek zit de zeldzame kleine modderkruiper.
Na 20 jaar is er dus alle reden voor een feestje! Op een rustige herfstdag in oktober konden 200 wandelaars genieten van een verrassend parcours door het gebied. We verlieten hiervoor de vaste wandelroute en toonden speciaal voor deze dag enkele verborgen pareltjes.
Onderweg werden de wandelaars verrast met informatie over paddenstoelen en over de grote zoogdieren in ons gebied: ree, bever en otter.

Onder een grote eik wachtte Hilde hen op met leuke verhalen over de bever. Het Korpus Kwartet liet met impressies uit hun programma Wald prachtige hoornmuziek door het bos galmen.
Voor kinderen was er een woordzoektocht die hen leerde dat bevers een burcht bouwen. Na de wandeling konden ze in het veldcafé bio-bruisballen maken in een flesje, een rijgsnoer voor hongerige vogels maken van pinda’s en appelstukjes, en een bever, vleermuis of sneeuwuil knutselen.
We blikken heel erg tevreden terug op ons feest in het bos. En dit dankzij meer dan 30 lokale vrijwilligers. Het is die grote vrijwilligersploeg waar we nog het meest trots op zijn. Nogmaals een dikke dankjewel voor iedereen die het mogelijk maakte!
© Femke Knobbe
Nieuwtjes
Nieuwe coördinator in het bezoekerscentrum


Geschenkverpakking
biobier
Verras bierliefhebbers eens met een lekker geschenk. In het bezoekerscentrum vind je cadeauverpakkingen met vier dikbuikflesjes bio-bier. Ofwel gevuld met vier flesjes Dale, het bio-bier dat exclusief voor Natuurpunt
Mechels Rivierengebied en buurafdeling
Oude Spoorweg gebrouwen wordt. Ofwel met vier verschillende flesjes Gageleer: Original, Superior Dark, Sour White en Alcohol free.
De hele winter kan je ‘onze’ Dale ook per bak kopen in het bezoekerscentrum. Vooraf te bestellen via bc.mechelsrivierengebied@ natuurpunt.be.
Prijs geschenkverpakkingen: 17 euro.
Prijs bak Dale: 36 euro (+ leeggoed 8 euro)
Dankjewel Ann
Begin november vierden we Ann Pinceel, coördinator van Bezoekerscentrum Mechels Rivierengebied. Zij zal, na een carrière van 27 jaar bij Natuurpunt, genieten van een welverdiend pensioen.
Haar afscheidsdrink trok vele vrijwilligers die ze door de jaren heen wist te raken met haar aangename, gedreven persoonlijkheid en ideeën.
Welkom Annelies
Annelies Ceuppens neemt de fakkel over. Zij is reeds enkele jaren tewerkgesteld bij Natuurpunt en kijkt vol enthousiasme uit naar de samenwerking met de vele helpende handen die deze afdeling, en bij uitbreiding het Natuurpark, dragen.
Ze is bereikbaar via het gekende adres: bc.mechelsrivierengebied@ natuurpunt.be.

Annelies (l) en Ann (r) © Raf Van Der Veken
Knottende bever
Op de Dag van de Natuur werden er in Willebroek knaagsporen van een bever aangetroffen. Niets speciaals natuurlijk, behalve de plaats waar de sporen werden gevonden.
Tijdens deze natuurwerkdag hadden de vrijwilligers gemaaid en maaisel afgevoerd. Er moesten ook nog twee wilgen geknot worden. Boven in de knotboom zagen ze de knaagsporen, op zo’n 2 meter boven de grond. De knotboom waar de takken waren afgeknaagd, was langs één zijde ingerot tot op de grond en was daardoor makkelijk toegankelijk. Maar het blijft toch een straffe vaststelling, bevers die kunnen knotten.
6 januari, 5 februari en 3 maart Natuurpint
Kern Mechelen organiseert elke maand een 'Natuurpint' rond een interessant thema. Hét moment om andere Natuurpunters te ontmoeten en gezellig samen te zijn. Of je nu gewoon geïnteresseerd bent of je je al jarenlang inzet als vrijwilliger: iedereen is welkom!
Telkens van 19u45 tot 22u.
Afspraak: bezoekerscentrum, Muizenhoekstraat 7, Muizen
Aanmelden via de activiteitenagenda op www.natuurpunt.be/np-mrg
Dinsdag 6 januari Nieuwjaarsdrink kern Mechelen

Naar goede gewoonte zet kern Mechelen het nieuwe jaar in met een Natuurpint: we heffen het glas op 2026, blikken even terug op wat we met Natuurpunt het voorbije jaar in Mechelen allemaal bereikt hebben en kijken vooruit naar het nieuwe jaar. Kom zeker af: er beweegt veel rond onze natuur en dat is meestal nog meer dan je beseft!
Donderdag 5 februari Op stap in het donker
In het donker beleef je de natuur op een andere manier. Zeker in de winter kan het écht donker zijn en ben je aangewezen op geluiden of het licht van een zaklamp. Samen met Filip Van den Wyngaert genieten we van de stilte en kijken eens met een warmtebeeldcamera naar het landschap, alsof we met de ogen van een roofdier kijken. Na de wandeling sluiten we in het bezoekerscentrum af met een drankje.
Dinsdag 3 maart Het Mechelse bijenplan
Wist je dat er meer dan 300 bijensoorten zijn in Vlaanderen? En dat vele van deze soorten bedreigd zijn? Om deze mooie en belangrijke insecten te beschermen, is het cruciaal om te weten welke soorten zich waar bevinden en op welke manier ze beter beschermd en versterkt kunnen worden. Om de bijen in Mechelen beter te beschermen, heeft Natuurpunt Studie tijdens de vorige legislatuur een bijenplan opgemaakt. Wat leert ons dat over de bijen in Mechelen? Hoe kunnen we daar als Natuurpuntvrijwilligers aan bijdragen? Bijenexpert Jens D’Haeseleer komt het ons vertellen.
Vrijdag 16 januari Spelletjesavond in het bezoekerscentrum

Klaar voor de wintereditie van onze natuurspellenavond?
Op 16 januari is het weer verzamelen geblazen in het bezoekerscentrum. Zoals altijd hebben we een heleboel spellen in een natuurthema verzameld. Koen zorgt voor een toegankelijke speluitleg en helpt je graag op weg.
Een greep uit het aanbod: Cascadia, Forest Shuffle, Photosynthesis, Mycelia, Bosbuit, Ecosystem en Wingspan.
We beginnen eraan om 19u30. Drank is verkrijgbaar aan democratische prijzen, wij voorzien een hapje.
Graag inschrijven via www.natuurpunt.be/np-mrg
© Koen van Vooren
© Wim Candries
Zaterdag 31 januari Algemene Vergadering Natuurpunt De Putter
Natuurpunt De Putter houdt een algemene jaarvergadering met aandacht voor de jaarrekeningen, bestuursaangelegenheden, patrimonium en beheer. Ook het programma voor 2026 wordt voorgesteld. Peter Hendrickx spreekt over de werking van Observation, de nieuwe naam voor waarnemingen.be, en het belang ervan voor Putte.
Iedereen welkom!
14u, lokaal Natuurpunt De Putter, Tinstraat 9B, Putte
Inschrijven via Lucien Verschoren, 0496 98 64 39
Nieuwjaarsactiviteiten van de Kernen
In Bonheiden, Mechelen, Sint-Katelijne-Waver en Willebroek houden ook de kernen hun lokale algemene vergadering of nieuwjaarsactiviteit. Wil je je engageren of ben je gewoon nieuwsgierig naar de werking van Natuurpunt in jouw gemeente? Welkom.
Dinsdag 6 januari kern Mechelen
Natuurpint / nieuwjaarsdrink
19u45 - 22u, bezoekerscentrum
Meer info en inschrijven: www.natuurpunt.be/np-mrg
Maandag 12 januari kern Bonheiden
Aan de hand van een fotoreportage overlopen we het jaar 2025 en we maken plannen voor 2026. Wij zorgen voor een hapje en een drankje. 20u, bezoekerscentrum
Meer info bij Diane: diane.appels@skynet.be
Donderdag 22 januari kern Willebroek
We blikken terug op het feestjaar 2025 waarin we het 20-jarige bestaan van de Biezenweiden vierden.
20u, De Schalk, vergaderzaal 1 - Stadionlaan 2A, Willebroek

Laat weten aan Ine als je erbij wil zijn: ine.colpaert@gmail.com.
Vrijdag 6 februari kern Sint-Katelijne-Waver

We overlopen de activiteiten van 2025 met foto’s, lichten onze financiën toe en bekijken wat we in petto hebben voor 2026 met de klemtoon op de activiteiten waarmee we toeleven naar 27 september, onze viering van 30 jaar Hondsbossen. We maken er een gezellige avond van. Iedereen is welkom.
19u30 - 22u, Brasserie De Plek van WZC Bosbeekhof, Wilsonstraat 38, Sint-Katelijne-Waver
Meer info bij Godelieve, godelieve-jans@telenet.be. Aanmelden mag, maar moet niet.


Vrijdag 13 maart
Algemene Vergadering Natuurpunt Mechels Rivierengebied Natuurpunt is een democratische vereniging. Daarom is het op vrijdag 13 maart weer zover: de jaarlijkse Algemene Vergadering (AV) van Natuurpunt Mechels Rivierengebied. Al onze leden en vrijwilligers hebben dan het recht om hun mening te geven over de werking van onze afdeling.
Daar blijft het echter niet bij: we beschouwen de AV vooral als een moment om iedereen te informeren en om gezellig samen te zijn. Wil je meer te weten komen over wat we met onze Natuurpuntafdeling doen? Wil je onze kernen beter leren kennen? Wil je weten hoe en waar we het voorbije jaar op ingezet hebben en wat we het komende jaar plannen?
Heb je zin om vrijwilliger te worden en wil je meer weten? Kom dan zeker af!
Wat staat er zoal op het programma:
• Voorstelling van de werking van onze vier kernen (Bonheiden, Mechelen, Sint-Katelijne-Waver en Willebroek) en het bezoekerscentrum;
• Voorstelling van enkele lopende projecten;
• Goedkeuring van het bestuur en verkiezing nieuwe bestuurders;
• Goedkeuring van onze stemgerechtigden op de nationale AV;
• Financiën van onze afdeling;
• Maar vooral: bijpraten en gezellig samenzijn!
Praktisch:
Je bent welkom vanaf 19u15 in Brasserie De Plek, WZC Bosbeekhof, Wilsonstraat 28, Sint-KatelijneWaver (ingang zijkant gebouw, waar de Natuurpuntvlag hangt). Start om 19u30. Overdekte fietsenstalling voor het gebouw.
Parking naast het gebouw. Als die parking vol is, rij dan verder en neem de 1ste straat rechts (richting Hondsbossen), dan weer rechts naar zaal Offendonk. Hou rechts aan, parkeer voorbij de mooie containers van de Fietsbieb en stap binnendoor over de eerste parking naar de Brasserie. Inschrijven (handig maar niet verplicht): www.natuurpunt.be/np-mrg
Paddenoverzet
Binnen enkele maanden is het weer zover, dan ontwaken de inheemse amfibieën uit hun winterslaap en gaan ze op pad. Ze trekken instinctief naar een voortplantingspoel in de buurt van hun winterverblijf om er nakomelingen te verwekken. De laatste jaren gebeurt dat vroeger en vroeger, vaak al eind januari, wanneer het regent en de temperatuur boven 7 °C stijgt. Soms moeten de dieren een weg oversteken en dan vallen er verkeersslachtoffers.
Putte
In Putte gaan ook dit jaar paddenoverzetacties door in de Schaapstraat en de Sikkelstraat. In de Schaapstraat beperken we ons tot een raapactie, in de Sikkelstraat plaatsen we 100 meter scherm aan de vijver van de historische hoeve. Na melding van verkeersslachtoffers, gaan we ook overzetten in de Grasheideweg op de grens tussen Putte en Schriek. Helpers steeds welkom.

Coördinator: Peter Hendrickx, peter_hendrickx@belgacom.net, 0471 53 18 85
Bonheiden
In Bonheiden staan vier teams vrijwilligers klaar om de padden, kikkers en salamanders over te zetten op plaatsen waar er veel trek is. Met de logistieke hulp van de gemeente slagen zij er elk voorjaar in honderden amfibieën te redden. Met succes, zo blijkt uit hun tellingen. Helpende handen zijn welkom! De overzetacties gaan door in de Koningin Astridlaan, de Peerlaarstraat, de Molenlei en de Bleukstraat. Coördinator: Agnes Cannaerts, 0478 29 87 09
© Diane Appels
Willebroek
Ook in Willebroek moeten we zorgen dat we er op tijd bij zijn. We plaatsen de paddenschermen op zaterdag 31 januari. Afspraak om 9u op de parking van het Broek in de Broekstraat, Blaasveld.
Vanaf dan zorgt een hele ploeg ervoor dat de emmers 's morgens en 's avonds leeggehaald worden. Wil je graag een paddenraaptoer voor je rekening nemen? Kom gerust eens proberen! Als dit nieuw is voor jou kan je al eens meelopen met een ervaren raper. Het is echt leuk om zo vroeg in het jaar de natuur al te zien wakker worden!
Info en aanmelden: Ine Colpaert, ine.colpaert@gmail.com
Sint-Katelijne-Waver en Walem
In Sint-Katelijne-Waver is een ploeg actief in de Rozendaalweg en de Kuikenstraat. Daar zijn momenteel geen extra helpende handen nodig. Voor de overzetacties in het Schrans, de Waterstraat, de Lintseheide en de Donderheide zijn wel extra medewerkers welkom. Ook voor Battenbroek in Walem (Mechelen) zoeken we nog hulp.
Coördinator: Walter, walter_van_camp@hotmail.com, 0474 69 34 23
Kalender 2026
Haal nog vlug een kalender in het bezoekerscentrum. Met elke maand een prachtige foto gemaakt door gepassioneerde natuur- en landschapsfotografen is de Natuurpuntkalender 2026 een leuk nieuwjaarscadeautje. De kalender meet 20 x 30 cm en heeft veel schrijfruimte.
Prijs: 12 euro

vaca tuurna
Gezocht: Helden achter de schermen!
Bij Natuurpunt draait alles om natuur, maar zonder goede omkadering staan we nergens. Daarom zoeken we versterking voor twee cruciale pijlers van onze vereniging. Ben jij de schakel die we missen?
1 Materiaalmeester (M/V/X)
Jij bewaart het overzicht over het materiaal in het bezoekerscentrum. Enkele kleine tenten, borden, bekers en thermossen: jij zorgt dat alles zijn vaste plek heeft en netjes klaar staat voor de volgende actie. Geen zware fysieke arbeid, wel zorgen voor orde en structuur zodat de vrijwilligers nooit misgrijpen.
2 Topper voor het Bezoekerscentrum
Zorg jij liever voor een warme ontvangstomgeving? We zoeken iemand die ons bezoekerscentrum met bijbehorende winkel- en horecahoek laat stralen. Van de vloer dweilen en kasten afstoffen tot meedenken over de winkelinrichting: jij ziet werk liggen en pakt het zelfstandig aan. Meedenken over de aanpak wordt zeker geapprecieerd: we zouden bijv.mensen met een beperking kunnen ondersteunen bij een zinvolle dagbesteding... Er ligt nog veel open.
Iets voor jou? Of je nu kiest voor één van beide taken of een combinatie ziet zitten, we verwelkomen je graag in onze vrijwilligersgroep.
Meld je aan via bc.mechelsrivierengebied@natuurpunt.be. Annelies neemt nadien graag contact met je op voor een kennismaking.



Beleidsnieuws
Onzichtbare vervuiling: hoe gaat onze natuur er mee om?
Vandaag de dag zijn er veel bedreigingen voor onze natuur, de een al zichtbaarder dan de ander. Onze slechte ruimtelijke ordening en versnipperde natuur zijn goed waar te nemen en de veranderende weerpatronen door klimaatverandering leggen ons als mens evengoed het vuur aan de schenen. Als het gaat over de stoffen die op microscopisch niveau onze natuur beïnvloeden, dan is het moeilijker om de vinger aan de pols te houden. Heel vaak weten we niet eens wat de grote uitdagingen zijn, laat staan dat we ze meten en opvolgen. Hoe deze vervuilende stoffen, ook wel emergente polluenten genoemd, onze natuur kunnen beïnvloeden, wordt toegelicht aan de hand van drie gevallen.
Eerste case: brand van het hoofdpodium van Tomorrowland

resten brand podium Tomorrowland © Diane Appels
We gaan héél even terug in de tijd, namelijk naar deze zomer. In juni stond heel Vlaanderen in rep en roer: het hoofdpodium van Tomorrowland was afgebrand. De rookpluim die zich toen vormde, verspreidde afvalresten van dat podium over een groot deel van ons afdelingsgebied. Vrijwilligers en wandelaars vonden nog dagen nadien verbrande stukken piepschuim en andere stoffen, wat tot grote zichtbaarheid in de media leidde. Echter, zodra het begon te regenen, vielen deze reeds beschadigde stukjes afval uiteen en leken ze te verdwijnen. Verdwijnt zoiets echter? Hoewel we over de specifieke stoffen, en hun impact op de natuur, moeilijk uitspraken kunnen doen, geeft onderzoek aan dat vele fijne materialen, resten van onze moderne maatschappij, zich overal kunnen verspreiden.
Microplastics zijn hier vandaag de dag het bekendste voorbeeld van: met wind, water en op andere wijze verspreiden ze zich overal in onze leefomgeving en komen ze steeds meer voor in de ecologische kringloop.1 Het is echter moeilijk om deze diverse groep aan polluenten goed in kaart te brengen. Welke gevolgen ze hebben op bv. onze lichamen en ziekteverspreiding is nog lang niet duidelijk, maar wel voorwerp van onderzoek. Welke gevolgen ze voor de natuur hebben, is minder helder. Het is wel aannemelijk dat wat voor ons als mensen kwalijk is, ook voor de vele diersoorten die ons omringen kwalijk is.
Tweede case: PFAS in Broek De Naeyer en de Barebeek
Microplastics die we verspreiden zijn maar één van de vele voorbeelden van hoe lucht, land en water lang niet meer veilig zijn voor onze invloed en van hoe weinig we weten. Er zijn echter stoffen waar we al langer van weten dat ze een negatieve invloed hebben op onze leefomgeving. Als we naar de bodem kijken, staan zware metalen al geruime tijd op de radar. Een categorie van stoffen waar we ons op bodemvlak de laatste jaren steeds meer zorgen over maken, is de groep van PFAS. Ondertussen klinkt dit velen bekend in de oren, en ook wetenschappelijk is het steeds duidelijker wat de problematiek is en wat er gemeten moet of zou kunnen worden (al is ook deze groep divers en lang nog niet volledig in kaart gebracht). Waar echter niet iedereen bij stilstaat, is dat PFAS niet alleen schadelijk zijn voor ons als mens, maar zich ook door onze leefomgeving verspreiden. In onze regio zijn er verschillende hotspots gekend: Broek De Naeyer in Willebroek, maar evengoed de Barebeek. Typisch zijn dit locaties met een industrieel verleden: zo is Broek De Naeyer vervuild door de fabriek die daar jarenlang gevestigd was, terwijl de Barebeek wellicht beïnvloed is (maar dit is niet met volle ze-
1 Zie bijvoorbeeld Sajjad, Muhammad, et al. "Microplastics in the soil environment: A critical review." Environmental Technology & Innovation 27 (2022): 102408.
• Beleidsnieuws

kerheid bevestigd) door het gebruik van PFAShoudende blusmaterialen op de luchthaven van Zaventem. De bronnen van de Barebeek bevinden zich daar immers vlakbij. PFAS zijn meestal bioaccumulerend: het zijn stoffen die zich opstapelen in een lichaam en na verloop van tijd een kritische drempel bereiken. Dat vloekt met de aanwezigheid van zeldzame soorten zoals de otter of plannen om meer vismigratie op onze waterlopen te krijgen. Om deze problemen op te lossen zijn dure ruimings- of saneringsprojecten nodig, terwijl we vele stoffen die tot de PFASgroep behoren nog beter in kaart moeten brengen en hun interacties amper begrijpen.
Derde case: watermonsterscampagne als burgerwetenschap
Als derde case is het tijd voor burgerwetenschap. Eerder dit jaar namen vele burgerwetenschappers, waaronder vele Natuurpunters, de tijd om in een waterloop in hun buurt stalen te nemen voor de Watermonsterscampagne. Dit onderzoek bracht het voorkomen van de bacterie E. coli in kaart. Escherichia coli is maar één van de mogelijke ziektekiemen in onze waterlopen, maar ze geeft wel een goed beeld van waar ongezuiverd water in onze waterlopen terechtkomt. Waar dat gebeurt, zijn er vaak nog veel andere polluenten aanwezig. Het kan dan gaan om meststoffen, maar evengoed om medicijnresten. Dit laatste is een bron van vervuiling waar moeilijk inzicht in te krijgen is en die nog moeilijker te zuiveren is. Op de recente studiedag van het Instituut voor Natuur- en Bosonderzoek over de Kaderrichtlijn Water, de richtlijn die onze doelen voor een goede waterkwaliteit vooropstelt, beargumenteerde professor Piet Verdonschot van de universiteit van Wageningen dat we een cocktail aan het creëren zijn waarvan de impact op verschillende soorten wellicht pas over vele jaren duidelijk wordt, terwijl insectenpopulaties in Europa nu al in vrije val zijn2
Laat het duidelijk zijn: er is veel werk aan de winkel. Als Natuurpunters zijn we elke dag opnieuw bezig met natuurherstel op het terrein, iets wat ons de laatste tijd op verschillende beleidsniveaus niet makkelijker gemaakt wordt, maar tegelijkertijd moeten we ons ook bewust zijn van de onzichtbare gevaren die dit werk nog complexer maken. Dat is geen opgave voor ons alleen: het is een maatschappelijke opgave om nog meer in te zetten op zuivering en het gebruiken van grondstoffen die we vlot en correct kunnen verwerken. Zoniet, dan zal onze omgevingskwaliteit wellicht nooit meer de lat kunnen halen die we onszelf stellen en sukkelen we van de ene PFAS-achtige crisis naar de volgende. Zoals toen ook bleek, heeft dat niet enkel een invloed op onze omgeving, maar ook op onze gezondheid: die twee hangen immers intrinsiek samen.
Beleidswerkgroep
2 Zie bijvoorbeeld Hallmann, Caspar A., et al. "More than 75 percent decline over 27 years in total flying insect biomass in protected areas." PloS one 12.10 (2017): e0185809.
Broek De Naeyer © Diane Appels
Watermonsterscampagne © Jimmy Luyckx
Gesignaleerd
Pijlstaarten, vervaarlijk ogende trekvlinders

Een bijzondere houtwesp
Begin oktober spotte Joris Boeykens een andere bijzondere zuiderling, de houtwesp Urocerus augur. Deze heeft zelfs geen Nederlandse naam. Het is het iets kleinere zusje van de reuzenhoutwesp, makkelijk van elkaar te onderscheiden door de brede gele en doorlopende
Op 10 oktober fotografeerde Kenny Ellis een wingerdpijlstaart in Putte centrum. De wingerdpijlstaart is een bij ons heel zeldzame trekvlinder. Pijlstaarten zijn nachtvlinders, de naam komt van het vervaarlijk ogende pijltje op het achterlijf van de imposante rupsen.
Dit jaar was er iets bijzonders. Pijlstaartvlinders uit Zuid-Europa en Noord-Afrika vonden massaal de weg naar onze contreien. Zo ook de wingerdpijlstaart waarvan trouwens ook de rups in Wiekevorst werd aangetroffen.
Naast de wingerdpijlstaart wist ook de walstropijlstaart Putte te vinden, hiervan werd de rups gesignaleerd. En verder, vooral in West-Vlaanderen, was er een ware invasie van de gestreepte pijlstaart. Gewoonlijk zien we hier enkel de kolibrievlinder verschijnen.
Wat was er aan de hand dat deze toch wel zuidelijke soorten dit jaar opdoken in Vlaanderen? Zeker hebben de hittegolven en bosbranden in het zuiden ze in beweging gezet, ook het warme najaar bij ons maakte van hun tocht mogelijk een succes. Op een paar kilometers kijken deze joekels van vlinders, soms wel een hand groot, ook niet. Ze kunnen ettelijke kilometers per nacht aan.

wingerdpijlstaart © Pixabay
houtwesp © Joris Boeykens
strepen achter de ogen van Urocerus augur. Houtwespen, een aparte familie van de bladwespen, leggen hun eitjes in hout. Coniferen, dennen en sparren, die lusten ze wel. Vrouwtjes zijn daarom uitgerust met een imponerende, maar voor ons ongevaarlijke legboor, waarmee ze eitjes kunnen droppen in het spinthout van hun favoriete naaldboom. Hout is taai en bevat ook niet zoveel voedingsstoffen. Het duurt wel twee à drie jaar voor de larve verpopt en er een houtwesp tevoorschijn komt.
Houtwespen komen niet op eigen vleugels aangevlogen. De meeste exemplaren worden als larve of pop aangevoerd met verpakkingshout of paletten. Oorspronkelijk is het een soort van Centraal- en Zuidoost-Europa.
De blonde ruiter, een spectaculaire waarneming

Een van de spectaculairste vogelwaarnemingen van het afgelopen jaar in de regio dateert van 25 september. Op die dag werd in het nieuwe overstromingsgebied Heindonk –Bovenzanden een blonde ruiter gezien.
De blonde ruiter is een kleine steltloper die je zelden in Europa aantreft. Het is een Amerikaanse soort die broedt in het noorden van Alaska en Canada en overwintert in Zuid-Amerika. Af en toe duikt een verdwaald exemplaar op in Europa. Voor de regio is het een eersteling en voor België is het pas de 13de keer dat de soort wordt waargenomen. Best wel spectaculair dus! Ook de waarneming zelf was spectaculair. Die dag was een slechtvalk erg actief aan het jagen boven Bovenzanden. Op een gegeven moment ging de valk vol in de aanval op een klein steltlopertje. Die kon de aanval ternauwernood afslaan en vloog vervolgens hoog de ijle lucht in. Gelukkig kon net dat moment op foto worden vastgelegd, zodat dit kleine vogeltje gedetermineerd kon worden als blonde ruiter.
Peter Hendrickx, Bert Mestdagh
blonde ruiter © origineel van Wikipedia (licentie)
Werken van start in Den Battelaer
Wie er is gaan wandelen, heeft het gemerkt: Den Battelaer was tijdens het najaar van 2025 het schouwtoneel van grote inrichtingswerken, waarbij de inzet van zware machines niet werd geschuwd. De werken zijn onderdeel van het Europese Wetlands4Cities-project. Wetlands (natte gebieden) functioneren als natuurlijke, gigantische sponsen die water vasthouden tijdens natte periodes en vertraagd afgeven bij droogte. Dit beschermt de omgeving tegen extreme droogte en wateroverlast.
Een stukje geschiedenis
Zoals op vele plaatsen heeft Den Battelaer, net omdat het natte natuur was, erg te lijden gehad onder de economische ontwikkeling van onze regio. In het begin van de 20ste eeuw leidde het rechttrekken van de Zenne er toe dat de natuur werd afgesloten van de rivier en volledig afhankelijk werd van regenwater. Onvermijdelijk heeft dit de natte habitats en biodiversiteit in het gebied negatief beïnvloed. In de verdere loop van de 20ste eeuw kwam daar bovenop de aanleg van een gigantische stortplaats voor huisvuil, het graven van twee enorme zandwinningsputten, het ontwateren en het beplanten met snelgroeiende populierenbestanden, en dies meer.
Toen De Wielewaal vzw (voorganger van Natuurpunt) de eerste percelen begon aan te kopen in de jaren 70 was dat om de vogelrijke habitats veilig te stellen tegen verdere teloorgang. Van droogte en hittestress was toen nog geen sprake, van verlies aan natuur en van biodiversiteit des te meer. In de 21ste eeuw plaatst de globale klimatologische verandering ons voor bijkomende uitdagingen.
Natuurherstel door LIFE Wetlands4Cities

Het Europese LIFE-project Wetlands4Cities is er in de eerste plaats om de klimatologische uitdagingen te helpen aanpakken, door de natuurlijke bufferfunctie van historisch natte gebieden te herstellen. Het project is een samenwerking van diverse partners en heeft tot doel om 360 hectare wetlands rond Mechelen en Tilburg opnieuw tot hun recht te laten komen tegen 2027. Den Battelaer is een belangrijk onderdeel van dit plan, samen met de valleien van Barebeek en Vrouwvliet.
De werken tijdens deze winter: twee maatregelen
De eerste maatregel bestaat uit het herstellen van de invloed van het historische bevloeiingssysteem op het beemdenlandschap. Er wordt voor gezorgd dat de Zenne-meander die door Den Battelaer kronkelt opnieuw water kan leveren aan de beemden. Tevens wordt het open karakter van het beemdenlandschap verbeterd door percelen die in de voorbije decennia overgroeid geraakten met wilgenopslag opnieuw als hooiweide in te richten. Oude irrigatiesloten worden geruimd en voorzien van een zacht hellende natuurlijke oevergradiënt. Op welbepaalde plaatsen worden buizen met bocht geplaatst, waarbij de 90° bocht de functie heeft om manueel de afvloeiing te kunnen regelen. Dat alles met het doel om de hydrologie en de infiltratie van water in het gebied te verbeteren.
De tweede maatregel bestaat uit het plaatsen van een bijkomende stuw op de plaats waar de Tiebroekloop in de Zenne uitmondt en het vernieuwen van een bestaande lekkende stuw in het hart van het natuurgebied. De stuwen hebben het vermogen om in de lente het waterniveau tot enkele centimeters boven het maaiveld vast te houden waardoor in de weilanden en rietvelden plasdras ontstaat. In de zomer en de herfst kan het waterniveau zodanig worden aangepast dat hooimachines hun werk kunnen doen en/of (na)begrazing met koeien kan plaatsvinden. De nieuwe stuwen imiteren als het ware het werk van de negentiende-eeuwse stuwen die weliswaar nog aanwezig zijn in het gebied, maar die niet meer operationeel zijn.
Naast het herstel van het waterbufferend vermogen van de natuur wordt door deze acties ook een rijker ecosysteem gecreëerd en een leefgebied voor zeldzaam geworden soorten zoals de kamsalamander, het porseleinhoen en de bruine kiekendief, allen belangrijke indicatorsoorten voor natuurlijke wetlands in onze regio.

Bevergaas wordt aangebracht ter bescherming van een
Deze acties vormen de eerste fase van een brede inspanning om het beemdenlandschap in Den Battelaer te herstellen.
De verdere planning
Intussen is ook de planning van de tweede fase van de werken van start gegaan: hydrologisch en historisch onderzoek, afstemming met stakeholders, aanvragen van vergunningen, uitschrijven van bestekken, voorbereiding van de aanbesteding, enz. De uitvoeringstermijn van deze tweede fase is het najaar van 2026. Deze “fase 2”-werken hebben onder meer tot doel om de voormalige zandwinningsputten (in de jaren 70 gegraven voor de aanleg van de E19) in te richten met zacht hellende oevers waar oevervegetatie en oeverbewoners alle kansen krijgen. Ook zal het zuidelijk deel van de oude Zenne-meander dat nog niet werd ingericht onder handen worden genomen zodat een doorlopende waterverbinding ontstaat van zuid naar noord.
Na afloop van deze werken zal Den Battelaer zich volop kunnen ontwikkelen tot een aantrekkelijk waterrijk beemdenlandschap waar het goed vertoeven is voor mens, dier en natuur.
Peter Delvaux, Patrick Van Herp
nieuwe stuw © Peter Delvaux
kalender
december

VR 26 december
Lichtjeswandeling in Putte
19u, lokaal De Putter, Tinstraat 9b, Putte
Inschrijven: Peter Hendrickx, 0471 53 18 85

ZO 28 december
Geen fu(u)t vandaag?
Mechels Broek
9u30 - 12u30, bezoekerscentrum, Muizenhoekstraat 7, Muizen
Inschrijven: www.natuurpunt.be/np-mrg
januari

ZA 3, 10, 17, 24 en 31 januari
Natuurwerkdagen
Zie blz 31

ZA 3 januari
Vette Vogelmiddag
Atelier voor kinderen van 1ste tot 6de lj 14u - 16u, bezoekerscentrum, Muizenhoekstraat 7, Muizen
Inschrijven: bc.mechelsrivierengebied@natuurpunt.be

DI 6 januari
Natuurpint
Nieuwjaarsdrink kern Mechelen
19u45 - 22u, bezoekerscentrum, Muizenhoekstraat 7, Muizen
Inschrijven: www.natuurpunt.be/np-mrg

ZO 11 januari
Hoe bibberen dieren de winter door?
Mechels Broek
9u - 12u, bezoekerscentrum, Muizenhoekstraat 7, Muizen
Inschrijven: www.natuurpunt.be/np-mrg
MA 12 januari
AV kern Bonheiden
20u, bezoekerscentrum, Muizenhoekstraat 7, Muizen
Info: diane.appels@skynet.be
VR 16 januari
Spelletjesavond
vanaf 19u30, bezoekerscentrum, Muizenhoekstraat 7, Muizen
Inschrijven: www.natuurpunt.be/np-mrg
DO 22 januari
AV kern Willebroek
20u, De Schalk, vergaderzaal 1- Stadionlaan 2A, Willebroek
Inschrijven: ine.colpaert@gmail.com

ZO 25 januari
Vogelweekend Mechels Broek
Welkom wintergasten! voor gezinnen met kinderen van 5 tot 12 jaar
vrij vertrek: 13u30 - 14u30, bezoekerscentrum, Muizenhoekstraat 7, Muizen

Vanaf 25 januari
Vogelspeurtocht in Biezenweiden, Hondsbossen en Mechels Broek voor gezinnen met kinderen van 5 tot 12 jaar
Doorlopend, met folder

Vanaf 29 januari
Cursus Meer natuur in je tuin? (volzet)

ZA 31 januari
Voorbereiding paddenoverzet Blaasveld 9u - 12u, parking Broekstraat, Blaasveld
Info/aanmelden: ine.colpaert@gmail.com
ZA 31 januari
AV Natuurpunt De Putter
14u, lokaal Natuurpunt De Putter, Tinstraat 9B, Putte
Inschrijven: Lucien Verschoren, 0496 98 64 39
februari

ZA 7, 14, 21 en 28 februari
Natuurwerkdagen
Zie blz 31

Vanaf 3 februari
Cursus Leren kijken naar vogels
DI 3, 10 en 24 februari,19u30 - 22u, bezoekerscentrum
Excursies: ZO 8 februari, 9u - 11u30 en ZO 8 maart, 8u - 10u30
Inschrijven: www.natuurpunt.be/np-mrg

DO 5 februari
Natuurpint: Op stap in het donker 19u45 - 22u, bezoekerscentrum, Muizenhoekstraat 7, Muizen
Inschrijven: www.natuurpunt.be/np-mrg

VR 6 februari
AV kern Sint-Katelijne-Waver
19u30 - 22u, Brasserie De Plek, WZC Bosbeekhof, Wilsonstraat 38, Sint-KatelijneWaver
Inschrijven (niet verplicht): godelieve-jans@telenet.be

ZO 15 februari
Landschapswandeling in Heindonk 13u30, kerk, Dorpsplein, Heindonk

ZO 22 februari
Vijf vogels - winterwandeling Biezenweiden
9u, ingang Biezenweiden thv verkeersdrempel, Stuyvenbergbaan, Heindonk

ZO 22 februari
Valentijn in het Mechels Broek 9u30 - 12u30, bezoekerscentrum, Muizenhoekstraat 7, Muizen
Inschrijven: www.natuurpunt.be/np-mrg
ZO 22 februari
(Fiets)tocht: Vogels kijken Klein Boom en Jutse plassen
13u30 - 17u, Jutse Plassen, parking Lierbaan, Putte (grens Koningshooikt)

ZA 7, 14, 21 en 28 maart
Natuurwerkdagen
Zie blz 31
ZO 1 maart
RUN FOR NATURE
Zie www.runfornature.be

ZO 1 maart
Parade aan de Zenne




9u -12u30, parking hondenweide, einde Eglegemweg (zijstraatje Bankstraat), Hombeek
DI 3 maart
Natuurpint: Het Mechelse bijenplan
19u45 - 22u, bezoekerscentrum, Muizenhoekstraat 7, Muizen
Inschrijven: www.natuurpunt.be/np-mrg
VR 13 maart
AV en nieuwjaarsdrink Natuurpunt
Mechels Rivierengebied
19u30, Brasserie De Plek, WZC Bosbeekhof, Wilsonstraat 28, Sint-KatelijneWaver
Inschrijven: www.natuurpunt.be/np-mrg
ZO 15 maart
Barebeekvallei
10u - 12u30, parking kerkhof, Kerkenbos, Muizen
ZO 22 maart
Beverwandeling in de Biezenweiden 14u, ingang Biezenweiden thv verkeersdrempel, Stuyvenbergbaan, Heindonk maart
Wist je dat?
Veenwortel
Veenwortel (Persicaria amphibia) heeft twee gezichten. Aan de waterkant vormt hij uitlopers met drijvende stengels, kale bladeren en overvloedige bloei.

En dan is er de landvorm. Die groeit tussen het gras, vaak ver van water. De landvorm heeft aanliggend behaarde bladeren en bloeit zelden of niet.
Veenwortel lijkt sterk op het nauw verwante perzikkruid (en op de beklierde duizendknoop). Perzikkruid en beklierde duizendknoop zijn eenjarige planten, pioniers die verschijnen wanneer lang begraven zaden na bijv. grondwerken plots aan het licht komen. Die pioniers bloeien die zomer massaal en vullen
zo de zaadbank in de grond aan. De landvorm van veenwortel houdt ook wel van grondverstoring maar ziet het op de lange termijn. Het is geen pionier maar een overblijvende plant. Onzichtbaar ondergronds lopen de wortelstokken (‘rhizomen’) meters ver uit, om daar nieuwe planten te produceren, klonen.
In de boomplantweide in Kauwendaal komt hij verspreid voor, een stengel met bladeren en zo goed als nooit bloei. Zelfs indien de landvorm van veenwortel bloeit, worden zelden zaden gevormd, want vaak zijn alle bloemen van eenzelfde plant (en zijn klonen) ofwel functioneel mannelijk ofwel vrouwelijk, waardoor je al twee aparte bloeiende planten nodig hebt en insecten voor kruisbestuiving, en hoe groot is die kans?

landvorm veenwortel
bloei landvorm veenwortel

De enige verklaring voor de ruime verspreiding is dat de boomplantweide in een vorig leven omgeploegd is en terug ingezaaid met gras. Of is het recenter gebeurd bij het maken van de plantgaten voor de boompjes? Of waren het mollen? Feit is dat het verplaatsen van een klein stukje van een wortelstok volstaat om ergens anders een volledige nieuwe plant te genereren. Klinkt bekend? Jawel, Japanse duizendknoop is een naast familielid dat zich bedient van eenzelfde strategie, met de gekende gevolgen.
Wij zien veenwortel gemakkelijk over het hoofd daar tussen al dat andere groen en had ik het woord ‘onopvallend’ al eens gebruikt? Als je toch zo’n plant vindt, dan

is dat wellicht doordat de bladeren vaker wel dan niet rood aangelopen vervormingen vertonen. Het is het werk van het vrouwtje van de veenwortelgalmug (Wachtliella persicariae). Dat verder totaal onschuldig, onooglijk beestje van amper twee millimeter lang, weet veenwortel feilloos te vinden. Ze spuit enkele eitjes in het blad van de plant. Het blad rolt op, zwelt en verkleurt na een tijd ook nog rood. Deze gal biedt tegelijk kost en inwoon aan de oranjeachtige, worstvormige larfjes van de galmug. Ze zitten er veilig, de behuizing is zo stevig dat je het blad niet kan ontrollen zonder het te breken. Zo veilig dat ze er ook verpoppen en de gal pas verlaten als mugje.
Moeder galmug ‘vergist’ zich wel eens en veroorzaakt dan een dergelijke gal op andere duizendknoopachtigen (helaas nog niet op de Japanse) maar het blijft een veenwortelgalmug. Die voorkeur heeft waarschijnlijk te maken met het efemere van het eenjarige perzikkruid, want de beestjes kunnen meerdere generaties op één jaar hebben en dan is een overblijvende plant als veenwortel een veiliger keuze voor de toekomst.

Tekst en foto's: Peter De Ridder
bloei veenwortel aan de waterkant

Zaterdag 3 januari
Vette vogelmiddag in het bezoekerscentrum

Atelier voor kinderen van 1ste tot 6de leerjaar © Els Devos
Je maakt de lekkerste vogelsnacks voor de vogels in je tuin! Als het koud is, hebben ze extra energie nodig en daar kan jij hen bij helpen!
14u - 16u, bezoekerscentrum, Muizenhoekstraat 7, Muizen 10 euro (8 euro voor Natuurpuntleden).
Info en inschrijven: bc.mechelsrivierengebied@natuurpunt.be
Zondag 25 januari
Grote
Vogelweekend Welkom wintergasten!

Oproep aan alle jonge avonturiers (5-12 jaar) en hun begeleiders!
Trek je warmste jas en stoere stapschoenen aan en duik mee in de wondere wereld van onze gevederde wintergasten.
Ontdek hoe vogels zich warm houden in de winter, waarmee ze zich voeden, luister of je hun geheime vogeltaal herkent en leer over hun indrukwekkende reizen. Langs een wandellus van 2,2 km staan onze gidsen klaar met spannende verhalen over trek, pluimen en bekken en de magie van vogels.

Heb jij de opdrachten die je krijgt, proberen te vervullen? Dan kan je op het einde rekenen op een warme verrassing. We verklappen nog niet te veel, maar … Je kan het drinken en er zit chocolade in. Weet jij al waarop je mag rekenen? Als jouw grote mensen ook een (klein) centje meenemen, kan je daarbij ook iets heel plat, rond en met een beetje suiker erop knabbelen. Nadat je hem hebt opgerold natuurlijk. We kunnen verder niets verklappen, het is immers een geheim.

Terwijl de kleine ontdekkers smullen, kunnen de volwassenen inspiratie opdoen in onze winkelhoek, om de vogels thuis ook verder te helpen.


Kom langs en beleef een onvergetelijke winterdag vol natuurpret!
Praktisch
Start: doorlopend (in kleine groepjes) tussen 13.30u en 14.30u, bezoekerscentrum, Muizenhoekstraat 7, Muizen. Einde activiteit rond 17u. Parkeren op de randparkings (zie blz 2)


Vanaf het Grote Vogelweekend
Flierefluiters en luistervinken
Vogelspeurtocht in drie natuurgebieden

Van 25 januari tot 31 maart kan je in drie natuurgebieden een leuke vogelspeurtocht doen:
• Mechels Broek: AS Adventure route - 5,5 km start aan bezoekerscentrum, Muizenhoekstraat 7, Muizen of aan begin wandelpad, parking De Nekker, Spuibeekstraat, Mechelen
• Hondsbossen: rode route - 2 km start aan kerk, Markt, Sint-Katelijne-Waver (op 600m van het bos)
• Biezenweiden: knooppuntenlus (155)-123-99-198-198-191-123-(155) - 4,3 km start aan ingang gebied, Stuyvenbergbaan aan verkeersdrempel, Willebroek Tijdens je speurtocht ga je op zoek naar 11 QR-codes langs het wandelpad. Bij elke code krijg je een tip en een geluid om de bijhorende vogelfoto op je folder te vinden. Van elke vogelnaam heb je een letter nodig om een letterpuzzel op te lossen. Wie daarin slaagt, maakt kans om een leuk vogelcadeautje te winnen.
Waar vind je de folder?
• In het bezoekerscentrum.
• In folderhouders aan de verschillende startpunten. Die voor de Hondsbossen hangt niet aan de kerk, maar net voorbij de ingang van het bos, aan de ezelsweide.
• Op www.natuurpunt.be/np-mrg kan je vooraf thuis het fotoblad downloaden op je smartphone of printen. Veel plezier!

krokusvakantie
Als je tijdens de openingsuren (uitzonderlijk elke namiddag open deze vakantie!) even het bezoekerscentrum binnen stapt na je vogelspeurtocht, kan je daar nog een kleine
‘vogels en nesten’ opdracht doen en krijg je een gratis kleurplaat en koek.






zomervakantie
woensdag 29, donderdag 30 en vrijdag 31 juli
Natuur.Kamp in het Mechels Broek voor kinderen van 2de tot 6de leerjaar

Drie dagen volop natuur ontdekken en beleven. 9u tot 17u (vrijdag van 8u)
Info/inschrijven: www.natuurpunt.be/np-mrg
© Ann Pinceel
De natuur in
Vrijdag 26 december
Lichtjeswandeling in Putte
Op tweede Kerstdag is iedereen welkom, samen met de familie. Breng een lantaarn of sfeervol lichtje mee, de nachten zijn lang en het is al vroeg donker. Vorig jaar zagen we tijdens de wandeling al de eerste salamander! Na de wandeling is er tijd voor een warme wijn of chocomelk om de kou te verdrijven, buiten rond de vuurkorf of lekker warm in ons lokaal.
19u, lokaal De Putter, Tinstraat 9b, Putte
Lengte wandeling: 5 km Kinderwagens en rolstoel kunnen mee.
Inschrijven: Peter Hendrickx, 0471 53 18 85
Zondag 28 december
Geen fu(u)t vandaag? in het Mechels Broek
Geen fut vandaag? Kan gebeuren. Tijdens de donkere wintermaanden heeft niet iedereen altijd evenveel energie.
Geen fuut vandaag? Dat zou jammer zijn, want deze prachtige vogels hopen we net wel te zien tijdens deze themawandeling.
Fut of geen fut, fuut of geen fuut, Koen vertelt je welke futensoorten in het natuurgebied te vinden zijn (en welke niet), hoeveel fut ze meestal hebben deze periode van het jaar en waar ze hun zomer- en winterdagen mee vullen.
Zin (en genoeg energie) om mee te gaan? Ook kinderen en jongeren zijn welkom. Stevige
Voor de meeste excursies moet je niet vooraf inschrijven. Indien wel vereist, staat dit erbij vermeld.
Voor annuleringen of als je op de wachtlijst wil, mail je naar bc.mechelsrivierengebied@natuurpunt.be
Met onze activiteitenflits ontvang je de meest recente informatie. Schrijf ervoor in met deze QR-code.

wandelschoenen of laarzen zijn aanbevolen. Een verrekijker is handig. Heb je er zelf geen, dan kun je er een lenen in het bezoekerscentrum. Honden kunnen niet mee.
9u30 - 12u30, bezoekerscentrum, Muizenhoekstraat 7, Muizen
Lengte wandeling: 5,5 km
Gids: Koen van Vooren, 0477 86 15 90 (berichtje)
Inschrijven: www.natuurpunt.be/np-mrg
Zondag 11 januari
Hoe bibberen dieren de winter door?
Hoe beleef jij de winter? Opgerold in warme dekens? Genietend van een frisse ochtendwandeling waarbij de lucht je adem bevriest? Of toch maar in het zonnige zuiden?
Op deze themawandeling ontdek je de verschillende aanpassingsstrategieën van dieren in de winter. Uiteraard hopen we ook een aantal soorten te zien. Benieuwd wie in het Mechels Broek overwintert?
Met een warme jas en aangepast schoeisel (wandelschoenen of laarzen) overleef je de ongeveer drie uur durende wandeling die ook geschikt is voor kinderen. Je verrekijker meebrengen, is zeker een goed idee. Een aantal is beschikbaar om uit te lenen in het bezoekerscentrum. Honden mogen niet mee.
9u - 12u, bezoekerscentrum, Muizenhoekstraat 7, Muizen
Lengte wandeling: 5,5 km
Gids: Koen van Vooren, 0477 86 15 90 (berichtje)
Inschrijven: www.natuurpunt.be/np-mrg
Zondag 15 februari
Landschapswandeling door de polder van Heindonk
Heindonk is een klein dorpje in een waterrijke omgeving, omringd door rust, groen en landelijke charme. Het is een plek waar landbouw, water en natuur elkaar ontmoeten, het ideale decor voor een frisse winterwandeling.

Onderweg wandelen we zeker door het Sigmagebied Bovenzanden, een belangrijk en bijzonder vogelgebied.
13u30, kerk, Dorpsplein, Heindonk
Lengte wandeling: 7 km
Gids: Wim Candries, 0472 29 87 32
Zondag 22 februari
Valentijn in het Mechels Broek
Brengen dieren elkaar bloemen wanneer ze elkaar het hof maken of is het eerder boem boem zonder bla bla?
Je hoeft geen partner te hebben om mee te stappen met onze Valentijnswandeling. Koen vertelt je over het liefdesleven van de dieren uit het Mechels Broek.
Stevige wandelschoenen of laarzen zijn aanbevolen. Honden zijn niet toegelaten.
9u30 - 12u30, bezoekerscentrum, Muizenhoekstraat 7, Muizen
Lengte wandeling: 5,5 km
Gids: Koen van Vooren, 0477 86 15 90 (berichtje)
Inschrijven: www.natuurpunt.be/np-mrg
Zondag 22 februari
Vijf vogels - winterwandeling in de Biezenweiden
Winter. De natuur vertraagt en alle (vogel-)leven verdwijnt uit het bos. Of toch niet?
Samen met Tom ga je op zoek naar vijf typische wintervogels voor deze regio. Voorzie aangepast schoeisel en kledij en eventueel een verrekijker.
Honden zijn niet toegelaten.
9u, ingang Biezenweiden thv verkeersdrempel, Stuyvenbergbaan, Heindonk (fietsknooppunt 10)
Lengte wandeling: 5 km
Gids: Tom Bal, tom.bal@telenet.be
Respect voor privacy
Tijdens activiteiten worden vaak foto’s genomen die dan in een later tijdschrift of op de website kunnen worden gepubliceerd.
Als je hiermee instemt, meld dit dan bij de inschrijving of bij de aanvang van de activiteit.
Rupel aan de Bovenzanden Heindonk © Diane Appels
Zondag 22 februari
(Fiets)tocht: Vogels kijken aan de Grote vijver van Klein Boom en de Jutse plassen
We gaan op (fiets)tocht om watervogels en andere wintergasten te spotten. Eerst bezoeken we de Jutse Plassen, een ondiep retentiebekken dat in de winterperiode dé plek is om eenden en steltlopers te zien.
Als we hier uitgekeken zijn, fietsen we of rijden we naar de Grote Vijver van Klein Boom, waar we rond 15u30 aankomen. De Grote Vijver van Klein Boom is een diepe ontginningsplas. Hier treffen we vooral duikende eenden en watervogels aan. Dit blijft niet zo. Met meer natuur als doel, zal de vijver in de nabije toekomst heraangelegd worden met ook ondiepere delen.
Nu de winter op zijn einde loopt, zijn beide gebieden ook een rustplek voor trekvogels op weg naar de noordelijke broedgebieden.
13u30 - 17u, Jutse Plassen, parking Lierbaan, Putte (grens Koningshooikt)
Lengte (fiets)tocht: 5 km
Info: Peter Hendrickx, 0471 53 18 85
Zondag 1 maart
RUN FOR NATURE
Zie www.runfornature.be
Zondag 1 maart
Parade aan de Zenne
Maart is de maand van de overgang in de natuur. Terwijl de zomergasten nog even op zich laten wachten en de meeste vogels al naar het noorden trekken, is er één plek waar het nog bruist van het leven: de Zenne en de Eglegemvijver! Kom deze schitterende laatste show van onze watervogels bewonderen! Soorten als pijlstaart, krakeend, bergeend, wintertaling en wilde eend zwemmen in maart op hun allermooist rond, volop bezig met de voorbereiding op trek of broeden.
Het unieke aan deze wandeling? De vogels foerageren hier op enkele meters van de dijk. Voor de verandering moeten we geen zware telescoop opstellen om de details van hun prachtige winterkleed te bewonderen. Met een beetje geluk horen we ook de Cetti’s zanger al fel zingen in de begroeiing en zien we mooie groepen zangvogels passeren op hun weg naar het noorden.
De wandeling loopt langs geasfalteerde dijken en is daarmee vlot toegankelijk. Een verrekijker is nuttig om details te zien, maar niet noodzakelijk. 9u -12u30, parking hondenweide, einde Eglegemweg (zijstraatje Bankstraat), Hombeek Lengte wandeling: 6,5 km Gids: Gust De Weerdt, 0477 77 10 19, august.de.weerdt@telenet.be
Jutse plassen © Diane Appels


Zondag 15 maart
Barebeekvallei
In normale omstandigheden is dit een echte uitwaaiwandeling in de vallei met de grote en de kleine Barebeek. De kans is groot dat we enkele ooievaars en sporen van bevers kunnen spotten. Wandelschoenen aanbevolen wegens modderig parcours.
10u - 12u30, parking kerkhof, Kerkenbos, Muizen
Lengte wandeling: 4,5 km
Gids: Peter De Ridder, 015 20 55 72, peter.petra@telenet.be
Zondag 22 maart
Beverwandeling in de Biezenweiden
Bevers zijn fascinerende dieren en het voorjaar is de beste tijd om hun aanwezigheid op te merken. Zodra de lente begint, worden de spo-
Natuurstudiewerkgroep Beneden-Dijle
Elke dinsdagvoormiddag gaat deze groep op stap, meestal in een natuurgebied in de buurt, soms verder weg. In de winter zijn het vaak landschapswandelingen en wordt er vooral naar vogels en mossen gekeken. Iedereen is welkom.
Voor het jaarprogramma en meer info kan je terecht bij Marie-Louise Selleslach, 015 51 59 02, ml.selleslach@telenet.be.
ren die ze achterlaten overal zichtbaar. In de wintermaanden vinden bevers weinig waterplanten, waardoor ze vooral aangewezen zijn op houtige gewassen. Dat betekent dat je nu veel knaagsporen kunt ontdekken: omgeknaagde stammen, potloodpunt-stobben en afgeschilde takken verraden waar ze actief zijn geweest.
Maar er is meer. Omdat de bomen nog kaal zijn en het bos nog niet is dichtgegroeid, vallen ook andere sporen extra goed op. Glijbanen langs de oever, looppaadjes en dammetjes tonen duidelijk dat bevers zich thuis voelen in de omgeving van de Biezenweiden. De dieren tonen zich overdag niet, maar hun sporen krijgen we zeker te zien.
14u, ingang Biezenweiden thv verkeersdrempel, Stuyvenbergbaan, Heindonk (fietsknooppunt 10) Lengte wandeling: 4 km
Gids: Jos Theunis, 0479 78 00 81

© André Ceulemans
ooievaar Barebeek © Wim Dirckx
Beheer
Plaatsen van slagbomen in natuurgebieden van De Putter

We beheren in Putte bijna 10 km wandelwegen die open staan voor wandelaars en honden aan de leiband.
Onze paden en onverharde wegen liggen meestal in natte gebieden die weinig draagkracht hebben. Moto’s, wagens en paarden zijn soms een probleem: wielen en hoeven zakken, vooral bij nat weer, diep in het slijk wat de wegen hobbelig maakt. De putten zijn dan moeilijk te herstellen en de paden blijven lange tijd moeilijk begaanbaar voor de wandelaars.
Om de toegankelijkheid te waarborgen zijn enkele slagbomen noodzakelijk. Wandelaars kunnen er makkelijk omheen en krijgen een veilige doorgang.
In De Peulisbossen is de toegang op deze manier recent beveiligd. In enkele nieuwe gebieden, Schopbos en de Krankebossen, wordt hieraan verder gewerkt in 2026.
BUSINESS FOR NATURE in Eeckelenbos
Op 6 maart ontvangt Natuurgebied Eeckelenbos een groep van waterzuiveringsbedrijf Pantarein in het kader van het project BUSINESS FOR NATURE.
De werknemers krijgen een teambuilding activiteit aangeboden waarbij ze kennis maken met het gebied en beheerwerken uitvoeren, waaronder boompjes aanplanten.
In ruil sponsoren ze onze afdeling voor de aankoop van natuurgebieden. Een winwin dus.

© Lucien Verschoren
© Frank Hadermann
NATUURWERKDAGEN

Om onze natuurgebieden in orde te houden is er veel werk. Natuurpunt kan daarvoor rekenen op vele vrijwilligers die letterlijk de handen uit de mouwen steken. Ook jij kan meedoen!
Meld je vooraf aan via de vermelde contactpersoon. Hij/zij laat je weten waar er afgesproken wordt.
NATUURPUNT MECHELS RIVIERENGEBIED
kern Bonheiden
ZA 24 januari, 10u tot 16u
ZA 28 februari, 10u tot 13u
ZA 28 maart, 10u tot 16u
Info/aanmelden: diane.appels@skynet.be
kern Mechelen
Battelaer
elke maandag, 9u tot 12u
Info: Patrick Van Herp, 0497 73 55 44 of Peter Delvaux, 0476 70 14 38
Kauwendaal
ZA 10 januari, 14 februari en 14 maart, 9u30 tot 12u30
Info/aanmelden: 0496 80 00 60, natuurpunt.kauwendaal@gmail.com (Kurt)
Mechels Broek
ZA 17 januari, 21 februari en 21 maart, 10u tot 15u
Info en aanmelden: tonynatuurpunt@gmail.com, 0479 08 35 12
Stuivenberg
ZA 24 januari, 15u tot 17u: schalmen en exoten bestrijden in populierenbos
ZA 21 maart, 9u tot 12u: 21 maart: verwijderen hekwerk en plaatmateriaal in beukenbos
Info/aanmelden: roel_schrauwen@hotmail.com, 0492 61 31 96
Zennebeemden
ZA 3 januari, 7 februari en 7 maart, 9u tot 12u
Info/aanmelden: zennebeemden@gmail.com, 0476 98 90 77 (Pieter)
kern Sint-Katelijne-Waver Waverwoud
ZA 17 januari, 21 februari en 21 maart, 10u tot 15u
Info/aanmelden: natuurpunt.skw@gmail.com
kern WILLEBROEK
Biezenweiden
ZA 24 januari, 28 februari en 28 maart, 9u tot 12u
Afspraak: ingang Biezenweiden thv verkeersdrempel, Stuyvenbergbaan, Heindonk
Info/aanmelden: ine.colpaert@gmail.com
Blaasveld
ZA 31 januari, 9u tot 12u: voorbereiding paddenoverzet
ZA 4 april, 9u tot 12u: afbraak paddenschermen
Afspraak: parking Broek, Broekstraat, Blaasveld
Info/aanmelden: ine.colpaert@gmail.com
NATUURPUNT DE
PUTTER
Schopbos
ZA 10 januari, 9u tot 12u
Afspraak: Zandweg, Grasheide
Info: Paul Oortman, 0498 75 12 48
Peultenbossen
ZA 7 februari, 9u tot 12u
Afspraak: parking Peultenbossen, zijweg Mechelbaan tegenover Krankhoevelei, Peulis
Info: lucien.verschoren@telenet.be
Krankebossen
ZA 7 maart, 9u tot 12u
Afspraak: voorbij Berkenstraat 34, Beerzel Info: jokke427@hotmail.com
Hoge Beemortel en zijstraten: opruimactie
ZA 21 maart, 14u
Afspraak: lokaal De Putter, Tinstraat 9b, Putte
Op de vraag van het gemeentebestuur om een aantal straten te adopteren in de strijd tegen zwerfvuil, koos Natuurpunt De Putter voor de omgeving van de Hoge Beemortel (7 km langs het Jan Gaspad, Kaaslei, Wolzakken, Dennenlaan, Safraanbergen en Berkenlei).
Info: albert.rijmenants@belgacom.net
Soms komen kleine groepjes van beheerteams samen om in hun gebied een klus uit te voeren. Wll je graag aansluiten bij een beheerteam, kijk dan even in de lijst op blz 39 en neem contact op met de verantwoordelijke.
•
werkdag Mechels Broek © Tony Van den Broeck
Inventariseren in Kauwendaal, een insider vertelt
Wintervlinders
Kauwendaal, zondag 15 december 2024, 9u45. Het heeft vannacht gevroren, op de bosgrond glinstert een laagje rijm, tussen de bomen sluimert nog wat nevel na. Het stadsbos oogt verlaten, overmeesterd door Koning Winter. Heel het stadsbos? Nee, een klein groepje biedt dapper weerstand aan de kou. Gewapend met macrolenzen en een flinke dosis wilskracht speuren ze een eikenrij af, op zoek naar een vlinder zonder vleugels, een vrouwtje wintervlinder.
Hierboven beschrijf ik het natuurstudiegroepje van Peter de Ridder, vlijtig aan het werk. 2025 was het tiende jaar op rij waarin zij de fauna, flora en fungi van Kauwendaal verkennen. Als beheerder ging ik twee jaar terug voor het eerst met hen op stap. Een aantal latere tochten zal ik nooit vergeten. Een jubileum verdient aandacht, hieronder geef ik dus graag wat uitleg.
Op expeditie in de achtertuin

Na die eerste keer was ik al meteen verkocht. Beheerders willen weten wat er leeft in hun gebied en inventariseren heeft voor mij ook iets nostalgisch. Soms voel ik me terug een kind, op ontdekking in de jungle. Dit alles in mijn eigen ‘achtertuin’, nota bene!
Met dit groepje de natuur intrekken, heeft best iets avontuurlijks. Neem nu de ‘beversafari’, begin 2025. Kauwendaal staat bekend voor zijn bevers, maar na de vernieling van hun dammen, vreesden we dat onze architecten zouden verkassen, moe van al dat gepest. Was dit gegrond? Peter en één Kauwendaler (mezelf) gingen op onderzoek in ons gebied. We trokken naar alle plaatsen waar eerder beveractiviteit werd vastgesteld en doken diep de wildernis in, weg van de begane paden. Op expeditie, in het spoor van de bever!
Een heel speciale vondst
Op een open plek in het bos vonden we omgevallen populieren met zeer recent beknaagde takken. Daarnaast een al even vers hoopje grote keutels, duidelijk van een planteneter, misschien een bever? Onwaarschijnlijk, omdat bevers hun keutels eerst opeten en de tweede darmpassage veilig in het water wegpoepen. Beverkeutels vind je daarom bijna nooit. Bovendien leken deze qua vorm meer op die van een beverrat, niet eerder waargenomen in ons gebied. Later opzoekwerk leerde ons dat een bever deze maaltijd (letterlijk) voor gezien laat als je hem/haar stoort bij de ontlasting op het land. De beschrijving van die curiositeit kwam goed overeen met onze vondst. De bever is dus nog steeds actief in ons gebied, zie ook de verse beverprenten, glijbanen en markeringen
Op zoek naar vermiljoenkevers - Peter De Ridder, Xavier Suykens, Johan Waumans © Stefan Maebe
die we vonden. Eén bever betrapten we bijna met de billen bloot, op klaarlichte dag. Dat was nog eens een primeur geweest!
Burgerwetenschap
Ik moet ook iets over Peters kompanen kwijt. Eén daarvan weet alles, maar dan ook álles, over paddenstoelen. Een andere is zot van korstmossen, maar vindt mossen behoorlijk saai. Er zijn de gebruikelijke ‘insectenfreaks’ en dan is er nog een bont allegaartje met brede natuurkennis én een goed oog, waartoe ik mezelf reken.
Zo een aanhang brengt veel waarnemingen aan, maar geen nood: ‘the master himself’ bundelt alles in een helder verslag. Zo kan je dit herbeleven vanuit je luie zetel, of voor de eerste keer als je er niet bij kon zijn. Smullen maar! Menno Schilthuizen in gedachten, zie ik in deze verslagen burgerwetenschap, vol waardevolle info voor beheerders.

Stefan Maebe, Ann Prosmans, een grote keizerlibel en Xavier Suykens © Peter De Ridder
Beste Peter, wanneer maak je een synthese van 10 jaar inventariseren in Kauwendaal? In boekvorm wordt dit ongetwijfeld een bestseller in het Mechels Rivierengebied - ook zonder foto van een kakkende bever.
Johan Waumans
Adverteren in ons tijdschrift?

Waarom?
• Bereik meer dan 4500 lid-gezinnen
• Bereik een bewust publiek: onze leden zijn milieubewust en betrokken bij natuurbehoud
• Versterk je imago: toon je inzet voor duurzaamheid en maatschappelijke verantwoordelijkheid
Wij bieden
• een derde van een pagina tegen 100€ of 50€ voor een zesde van een pagina
• zichtbaarheid online en offline
Interesse? Meer info? redactie-mrg@natuurpunt.be
Vorming
Vanaf 29 januari
Cursus Meer natuur in je tuin?
Deze cursus is volzet. Meer info op www.natuurpunt.be/mrg
Vanaf 3 februari
Cursus Leren kijken naar vogels
In de eerste les krijg je een inleiding: de functie van het verenkleed, de verschillende snavelvormen, de werking van de zintuigen, de levenscyclus, de biotoopkeuze.
De tweede avond wordt eerst ingegaan op hulpmiddelen zoals verrekijkers en veldgidsen, daarna begint het belangrijkste onderdeel: vogels leren herkennen. Dit wordt in de derde les verder uitgediept. Niet met portretten van een waslijst aan vogelsoorten, maar door samen te kijken naar veldkenmerken bij vogels en waar je het best op kan letten. Zo krijg je oog voor detail en leer je technieken om vogels te herkennen. Tot slot komt ook het aantrekken van vogels in de tuin aan bod.

Programma
Theorie: dinsdag 3, 10 en 24 februari, 19u30 - 22u, bezoekerscentrum
Excursies:
• zondag 8 februari, 9u - 11u30, in het Mechels Broek
• zondag 8 maart, 8u - 10u30, aan het Zennegat
Lesgever: Bastiaan De Ketelaere van Natuuracademie
Prijs: 75 euro (60 euro voor leden)
Inschrijven: www.natuurpunt.be/mrg
keep © Diane Appels
Vanaf 20 april
Cursus Grassen
Grasachtige planten hebben een slechte reputatie. Ze gaan door als lastig op naam te brengen en vormen weinig tot de verbeelding sprekende bloemen. Maar wie de moeite doet om met een loep de bloeiwijzen van grasachtige planten te bekijken, ontdekt een verbazingwekkende wereld.
In deze cursus maak je niet alleen kennis met veel voorkomende soorten uit de grassenfamilie (Poaceae), cypergrassenfamilie (Cyperaceae) en russenfamilie (Juncaceae), maar je gaat ook geleidelijk beseffen dat, mits een basiskennis van hun anatomie, grasachtige planten veel minder moeilijk herkenbaar zijn dan vaak beweerd wordt. En dat is niet zonder belang, gezien grasachtige planten in vele biotopen dominant zijn.
Programma
Theorie: maandag 20 en 27 april, 19u30 - 22u, bezoekerscentrum
Excursies: zaterdag 9 mei, 6 en 27 juni, 14u - 17u
Lesgever: Hans Vermeulen van Natuuracademie
Prijs: 75 euro (60 euro voor leden)
Inschrijven: www.natuurpunt.be/mrg



BLACK ANGUS VLEESPAKKETTEN

Steun de aankoop van natuurgebieden
Wil je de aankoop van natuurgebieden financieel steunen? Stort dan een gift op rekening
BE56 2930 2120 7588 van vzw Natuurpunt Beheer, Coxiestraat 11, 2800 Mechelen met vermelding van één van onderstaande projectnummers (en naam gebied). Vanaf 40 euro ontvang je een fiscaal attest.
Projectnummers van Natuurpunt De Putter
3716 Afdeling Natuurpunt De Putter
7145 Grote Vijver van Klein Boom
7169 Peulisbossen Putte
7236 Krankebossen
7253 Schopbos
7746 Hoge Beemortel
7818 Peultenbossen Putte
Projectnummer van Natuurpunt Mechels Rivierengebied: 3799 Mechels Rivierengebied
Met jouw steun herstellen we het groene hart van Vlaanderen. In onze regio werken we hard om versnipperde natuurgebieden met elkaar te verbinden. Dit groene landschap, doorkruist door beken en de rivieren aan onze rand (Dijle en Nete) biedt een thuis en leefruimte aan zeldzame dieren en planten zoals de nachtegaal, ijsvogel, dotterbloem, of de fascinerende levendbarende hagedis en de maretak. Samen werken we zo aan meer diversiteit en natuurbeleving!
Online lezen
Wil je ons tijdschrift (ook) gratis online lezen, vul dan het inschrijvingsformulier in op np-mrg.be/tijdschrift .
Daar vind je ook een formulier waarmee je de gedrukte versie kunt opzeggen. Zowel het online lezen als het opzeggen van de gedrukte versie zijn omkeerbaar. Uitproberen kan en mag. Wil je eerst een online nummer zien, dan kan dat via np-mrg.be/datwilikzien Ons digitaal archief vind je op issuu.com/redactie-mrg.



overal lezen . minder drukkosten . meer natuur . als pdf bewaren . digitaal archief
natuur.crypto 20
Op www.cryptochris.be vind je tips, meer opgaven en de oplossing.

Sint-Hubertuscollege, Sint-Bernardusinstituut
D buur van de mol en de regenworm
E Spaanse versie van de vogeltjesdans
H niet aangelengd met meel
hebberig roofdier
gewend aan het platteland






















Tinstraat 6 | 2580 Putte info@tim-machines.be 0474 75 83 56



















Schaapstraat 13 2580 Putte www.tcoolhof.be 0471 561 337
PLUKVELD BLOEMENWEIDE focus op inheemse en eetbare planten in omschakeling naar biologische teelt
PLANTENKWEKERIJ
10% korting voor leden Velt en Natuurpunt
boeketten en geplukte kruiden op bestelling
Dé partner voor tamme kastanje, robinia en eik. Eigen productie van palen, hekwerk, poorten, post & rail afsluiting in Mechelen. Bel ons op 015490218 of mail naar: hallo@portershout.Be


wild van planten
Waarvan akte
Een terugblik op 2025

Dit keer geen verhaal rond een nieuwe aankoop, maar een terugblik op een bewogen jaar met heel wat nieuwe kansen en uitbreidingen voor de natuur in onze gebieden. Na het grote aankoopjaar 2024 waarin we meer dan 34 ha aan de Mechelse natuur toegevoegd hebben, kunnen we toch ook tevreden terugblikken op 2025.
We verwierven een aantal ontbrekende puzzelstukjes in Den Battelaer en konden Stuivenberg uitbreiden.
Natte natuur en bosuitbreiding zijn de streefdoelen voor deze percelen, een blijvende bijdrage tot de klimaatrobuustheid van onze regio.
Intussen blijven onduidelijkheid rond subsidies en overheidsbeleid het voor ons een uitdaging maken om aankopen gefinancierd te krijgen. Maar met een financieel duwtje van jullie in de rug kunnen we dit blijven rondkrijgen. Onze aankopers zitten immers niet stil en hebben al een aantal mooie kansen voor 2026 in de pijplijn zitten.
Heel veel dank in naam van de natuur!
Storten mag dus, heel graag zelfs!
Op rekeningnummer BE56 2930 2120 7588 van Natuurpunt vzw met ve rmelding “project 3799 Mechels Rivierengebied”
Voor een gift vanaf 40 euro ontvang je een fiscaal attest. Zo betaalt de overheid een stukje mee en krijg jij via je belastingaangifte een deel terug.
Muyzenhuys © Mario Engels
Biezenweiden
(Broek De Naeyer)
(Blaasveldbroek)
Zennegat
Goorbosbeekvallei
Spoorwegzaten
Fort van Walem
Eeckelenbos
Kauwendaal
Warande
(Robbroek) Zuur Bemke
Jutse plassen
Bruinbeekvallei Waverwoud
Brede Zeyp
Hondsbossen Gasthuisbossen
Vossenbergbos
Zuurbossen
Stuyvenberg PUTTE Steenbeek
Peultenbossen
Peulisbossen
Cassenbroek 't Ven Mechels Broek
Zennebeemden
NATUURPUNT MECHELS RIVIERENGEBIED
kern Bonheiden
Bruinbeekvallei
Rudy Meeus
rudy.meeus@telenet.be, 0478 29 87 09
Cassenbroek, Mispeldonk en Pikhakendonk
Geert Van D’huynslager geertvandhuynslager@gmail.com, 0471 60 40 59
Joost Dewyspelaere joost.dewyspelaere@skynet.be, 015 51 69 97
kern Mechelen
Barebeekvallei
Philip Jackson
philip.jackson@natuurpunt.be, 0487 34 47 02
Battelaer, Warande en Zuur Bemke
Patrick Van Herp, patrick.vanherp@hotmail.com, 0497 73 55 44
Fort van Walem
Filip Van den Wyngaert, filip.vdw@telenet.be, 0476 25 37 45
Kauwendaal
Kurt Stevens
Karen Vandevyvere natuurpunt.kauwendaal@gmail.com, 0496 80 00 60
Mechels Broek
Tony Van den Broeck tonynatuurpunt@gmail.com, 0479 08 35 12
Gust De Weerdt august.de.weerdt@telenet.be, 0477 77 10 19
Stuyvenberg
Roel Schrauwen roel_schrauwen@hotmail.com, 0492 61 31 96
Mario Engels mario.engels2@telenet.be, 0499 55 29 96
Zennebeemden
Tom Boermans, 0497 51 83 63
Pieter Schepers, 0476 98 90 77 zennebeemden@gmail.com
Krankebossen
Grote vijver van Klein Boom
Voordonkse plassen
O ershoek
Schopbos
Hoge Beemortel
Barebeekvallei
Beneden-Dijlevallei
Pikhakendonk Mispeldonk
kern WilleBroek
Biezenweiden
Wim Candries, 0472 29 87 32
kern Sint-k atelijne-Waver
Gasthuisbossen, Hondsbossen, Vossenbergbos en Zuurbossen
Jimmy Luyckx jimmy.luyckx@gmail.com
Eeckelenbos en Spoorwegzaten
Frank Hadermann frank.hadermann@skynet.be, 015 31 55 05
Luc Fillée luc.fillee@telenet.be, 0473 34 22 72
NATUURPUNT DE PUTTER
Grote Vijver van Klein Boom
Albert Rijmenants albert.rijmenants@belgacom.net , 0479 71 41 77
Peulisbossen
Joeri Verrept joeri@verre.pt, 0484 49 94 57
Krankebossen
Joke Rijmenants
jokke427@hotmail.com, 0479 44 39 58
Hoge Beemortel
Albert Rijmenants 0479 71 41 77
Paul Oortman 0498 75 12 48
Schopbos
Paul Oortman 0498 75 12 48
Albert Rijmenants 0479 71 41 77
Peultenbossen
Lucien Verschoren lucien.verschoren@telenet.be, 0496 98 64 39
Steenbeekbossen
Liliane Verhulsel liliane.verhulsel@gmail.com, 0468 22 92 02
Voordonkse plassen
Toon Hasselman toon.hasselman@telenet.be, 0472 75 37 10

Afgiftekantoor 2800 Mechelen 1
P206001
driemaandelijks tijdschrift van Natuurpunt Mechels Rivierengebied en De Putter Afzender en VU: Frank De Roover - p/a Muizenhoekstraat 7 - 2812 Muizen
januari - februari - maart 2026
bpost
PB- PP
BELGIE(N) - BELGIQUE


















GEDRUKT DOOR